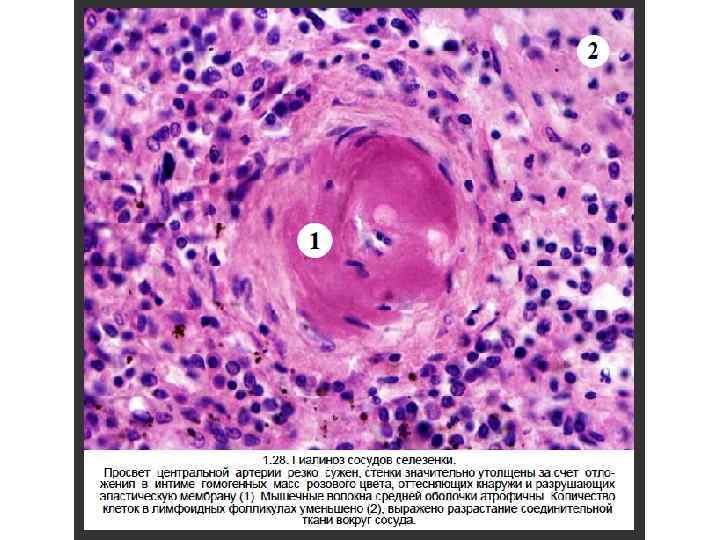

Нарушение белкового и жирового обменов.ppt
- Количество слайдов: 43
 Дистрофия (от греч. dys – «отклонение от нормы» и греч. trophe питание) – патологический процесс, в основе которого лежит нарушение тканевого и/или клеточного метаболизма, ведущее к структурным изменениям.
Дистрофия (от греч. dys – «отклонение от нормы» и греч. trophe питание) – патологический процесс, в основе которого лежит нарушение тканевого и/или клеточного метаболизма, ведущее к структурным изменениям.
 Трофика совокупность механизмов, определяющих метаболизм и структурную организацию клетки или ткани, необходимых для выполнения специализированной функции.
Трофика совокупность механизмов, определяющих метаболизм и структурную организацию клетки или ткани, необходимых для выполнения специализированной функции.
 механизмы поддержания трофики • Клеточные - обусловлены генетическим кодом • Внеклеточные обусловлены транспортными системами (кровь, лимфа) - интегративными системами (нервная, эндокринная, гуморальная)
механизмы поддержания трофики • Клеточные - обусловлены генетическим кодом • Внеклеточные обусловлены транспортными системами (кровь, лимфа) - интегративными системами (нервная, эндокринная, гуморальная)
 Проявления дистрофии • нарушение нормального содержания вещества (накопление, уменьшение) • изменение физико-химических свойств вещества • появление обычных веществ в нетипичных местах • появление не встречающихся в норме веществ в клетках, во внеклеточном веществе, стенках сосудов и строме органов
Проявления дистрофии • нарушение нормального содержания вещества (накопление, уменьшение) • изменение физико-химических свойств вещества • появление обычных веществ в нетипичных местах • появление не встречающихся в норме веществ в клетках, во внеклеточном веществе, стенках сосудов и строме органов
 Этиология дистрофии • • • гипоксия токсические вещества (в том числе токсины микроорганизмов) лекарства физические и химические агенты генетические повреждения приобретенные или наследственные дефекты ферментов (ферментопатии) вирусы дисбаланс питания заболевания нервной системы заболевания эндокринной системы нарушения состава крови или мочи при заболеваниях внутренних органов другие причины, ведущие к нарушениям клеточных и внеклеточных механизмов трофики
Этиология дистрофии • • • гипоксия токсические вещества (в том числе токсины микроорганизмов) лекарства физические и химические агенты генетические повреждения приобретенные или наследственные дефекты ферментов (ферментопатии) вирусы дисбаланс питания заболевания нервной системы заболевания эндокринной системы нарушения состава крови или мочи при заболеваниях внутренних органов другие причины, ведущие к нарушениям клеточных и внеклеточных механизмов трофики
 Классификация дистрофий 1. От вида нарушенного обмена – белковые, жировые, углеводные, минеральные, смешанные. 2. Исходя из преимущественной локализации метаболических нарушений – паренхиматозные, стромально–сосудистые, смешанные. 3. От влияния генетических факторов – наследственные, приобретенные. 4. По распространенности – общая, местная.
Классификация дистрофий 1. От вида нарушенного обмена – белковые, жировые, углеводные, минеральные, смешанные. 2. Исходя из преимущественной локализации метаболических нарушений – паренхиматозные, стромально–сосудистые, смешанные. 3. От влияния генетических факторов – наследственные, приобретенные. 4. По распространенности – общая, местная.
 Морфогенетические механизмы развития дистрофий 1. 2. 3. 4. 5. 6. Инфильтрация Декомпозиция Трансформация Извращенный синтез Шапероновый Убиквитиновый
Морфогенетические механизмы развития дистрофий 1. 2. 3. 4. 5. 6. Инфильтрация Декомпозиция Трансформация Извращенный синтез Шапероновый Убиквитиновый
 Шапероновый механизм диспротеинозов
Шапероновый механизм диспротеинозов
 ОБРАЗОВАНИЕ внутриклеточных накоплений • Накопления естественных эндогенных метаболитов, которые образуются в нормальном или ускоренном ритме, а скорость их удаления недостаточна. • Накопление эндогенных веществ, которые не могут метаболизироваться, как правило, вследствие генетического дефекта фермента. • Аккумуляция аномальных экзогенных веществ, которые клетка не может ни разрушить с помощью ферментов, ни транспортировать в другое место (например, частицы угля).
ОБРАЗОВАНИЕ внутриклеточных накоплений • Накопления естественных эндогенных метаболитов, которые образуются в нормальном или ускоренном ритме, а скорость их удаления недостаточна. • Накопление эндогенных веществ, которые не могут метаболизироваться, как правило, вследствие генетического дефекта фермента. • Аккумуляция аномальных экзогенных веществ, которые клетка не может ни разрушить с помощью ферментов, ни транспортировать в другое место (например, частицы угля).
 Причины развития жировой дистрофии печени 1. Экзогенные факторы - увеличение всасывания из кишечника продуктов гидролиза липидов и моносахаридов (глюкоза, фруктоза, галактоза), являющихся предшественниками глицеридов. 2. Эндогенные факторы включают: 1) усиление периферического липолиза (действие алкоголя, никотина, кофеина, катехоламинов, кортизола и др. ); 2) снижение утилизации жирных кислот гепатоцитом; 3) повышение синтеза липидов; 4) дефицит белков в гепатоците; 5) блокада ферментов, участвующих в синтезе липопротеидов очень низкой плотности и их секреции.
Причины развития жировой дистрофии печени 1. Экзогенные факторы - увеличение всасывания из кишечника продуктов гидролиза липидов и моносахаридов (глюкоза, фруктоза, галактоза), являющихся предшественниками глицеридов. 2. Эндогенные факторы включают: 1) усиление периферического липолиза (действие алкоголя, никотина, кофеина, катехоламинов, кортизола и др. ); 2) снижение утилизации жирных кислот гепатоцитом; 3) повышение синтеза липидов; 4) дефицит белков в гепатоците; 5) блокада ферментов, участвующих в синтезе липопротеидов очень низкой плотности и их секреции.
 Механизмы развития жировой дистрофии печени • чрезмерное поступление в гепатоциты жиров при липопротеидемии (алкоголизм, сахарный диабет, общее ожирение, гормональные расстройства); • повышенный синтез жиров гепатоцитами; • воздействие токсических веществ, блокирующих окисление жирных кислот и синтез липопротеидов в гепатоцитах гепатотропные интоксикации (этанол, хлороформ и др. ); • недостаточное поступление в печеночные клетки аминокислот, необходимых для синтеза фосфолипидов и липопротеидов (алипотропная жировая дистрофия печени, авитаминозы, болезни пищеварительной системы и синдромы мальабсобрбции).
Механизмы развития жировой дистрофии печени • чрезмерное поступление в гепатоциты жиров при липопротеидемии (алкоголизм, сахарный диабет, общее ожирение, гормональные расстройства); • повышенный синтез жиров гепатоцитами; • воздействие токсических веществ, блокирующих окисление жирных кислот и синтез липопротеидов в гепатоцитах гепатотропные интоксикации (этанол, хлороформ и др. ); • недостаточное поступление в печеночные клетки аминокислот, необходимых для синтеза фосфолипидов и липопротеидов (алипотропная жировая дистрофия печени, авитаминозы, болезни пищеварительной системы и синдромы мальабсобрбции).
 Жировая дистрофия печени (жировая инфильтрация; жировой гепатоз; стеатоз) патологический процесс, при котором происходит накопление капель жира внутри цитоплазмы и эндоплазматического ретикулума гепатоцита. Стеатоз может быть мелкокапельным, среднекапельным и крупнокапельным. При разрыве мембран гепатоцитов происходит слияние нескольких жировых капель с образованием жировых кист.
Жировая дистрофия печени (жировая инфильтрация; жировой гепатоз; стеатоз) патологический процесс, при котором происходит накопление капель жира внутри цитоплазмы и эндоплазматического ретикулума гепатоцита. Стеатоз может быть мелкокапельным, среднекапельным и крупнокапельным. При разрыве мембран гепатоцитов происходит слияние нескольких жировых капель с образованием жировых кист.
 Жировая дистрофия печени ( «гусиная печень» )
Жировая дистрофия печени ( «гусиная печень» )



 Жировая дистрофия миокарда патологический процесс, характеризующийся очаговым появлением в группах мышечных клеток, расположенных по ходу венозного колена капилляров и мелких вен, мельчайших жировых капель (пылевидное или мелкокапельное ожирение). Преимущественно поражаются кардиомиоциты в области трабекул и сосочковых мышц левого желудочка ( «тигровое сердце» ).
Жировая дистрофия миокарда патологический процесс, характеризующийся очаговым появлением в группах мышечных клеток, расположенных по ходу венозного колена капилляров и мелких вен, мельчайших жировых капель (пылевидное или мелкокапельное ожирение). Преимущественно поражаются кардиомиоциты в области трабекул и сосочковых мышц левого желудочка ( «тигровое сердце» ).
 Причины и механизмы развития жировой дистрофии миокарда. 1. Гипоксия (гипоксическая, циркуляторная, гемическая и тканевая) – нарушение окисления жирных кислот. 2. Интоксикация - нарушение окисления и карнитинчелночного механизма транспорта жирных кислот.
Причины и механизмы развития жировой дистрофии миокарда. 1. Гипоксия (гипоксическая, циркуляторная, гемическая и тканевая) – нарушение окисления жирных кислот. 2. Интоксикация - нарушение окисления и карнитинчелночного механизма транспорта жирных кислот.
 Жировая дистрофия миокарда ( «тигровое сердце» )
Жировая дистрофия миокарда ( «тигровое сердце» )


 Жировая дистрофия миокарда (судан III)
Жировая дистрофия миокарда (судан III)
 Жировая дистрофия миокарда (электронограмма)
Жировая дистрофия миокарда (электронограмма)



 Проявления белковой дистрофии (диспротеинозы) • Внутриклеточные – зернистая, гиалиново-капельная дистрофия; гидропическая (тельце Русселя; тельце Маллори). • Внеклеточные – мукоидное набухание; фибриноидное набухание; гиалиноз; амилоидоз.
Проявления белковой дистрофии (диспротеинозы) • Внутриклеточные – зернистая, гиалиново-капельная дистрофия; гидропическая (тельце Русселя; тельце Маллори). • Внеклеточные – мукоидное набухание; фибриноидное набухание; гиалиноз; амилоидоз.






 Гиалиновые изменения вид повреждения при котором ткань или клетка приобретают гомогенное розовое окрашивание, подобное окрашиванию основного вещества гиалинового хряща при использовании гематоксилина и эозина. Различают местный и распространенный гиалиноз.
Гиалиновые изменения вид повреждения при котором ткань или клетка приобретают гомогенное розовое окрашивание, подобное окрашиванию основного вещества гиалинового хряща при использовании гематоксилина и эозина. Различают местный и распространенный гиалиноз.
 Виды гиалиновых изменений 1. Внутриклеточные гиалиновые депозиты - накопления белка (гиалиново-капельная дистрофия, тельца Русселя и Маллори). 2. Гиалиноз – внеклеточное (в стенках сосудов и межклеточном веществе) отложение гиалина.
Виды гиалиновых изменений 1. Внутриклеточные гиалиновые депозиты - накопления белка (гиалиново-капельная дистрофия, тельца Русселя и Маллори). 2. Гиалиноз – внеклеточное (в стенках сосудов и межклеточном веществе) отложение гиалина.
 Процессы, предшествующие гиалинозу • Плазматическое пропитывание • Фибриноидное набухание и фибриноидный некроз • Воспаление • Некроз • Склероз
Процессы, предшествующие гиалинозу • Плазматическое пропитывание • Фибриноидное набухание и фибриноидный некроз • Воспаление • Некроз • Склероз
 Виды гиалина • 1. Простой • 2. Сложный • 3. Липогиалин
Виды гиалина • 1. Простой • 2. Сложный • 3. Липогиалин
 Системная дезорганизация соединительной ткани • • 1. Мукоидное набухание 2. Фибриноидное набухание/некроз 3. Клеточная реакция 4. Гиалиноз/склероз
Системная дезорганизация соединительной ткани • • 1. Мукоидное набухание 2. Фибриноидное набухание/некроз 3. Клеточная реакция 4. Гиалиноз/склероз